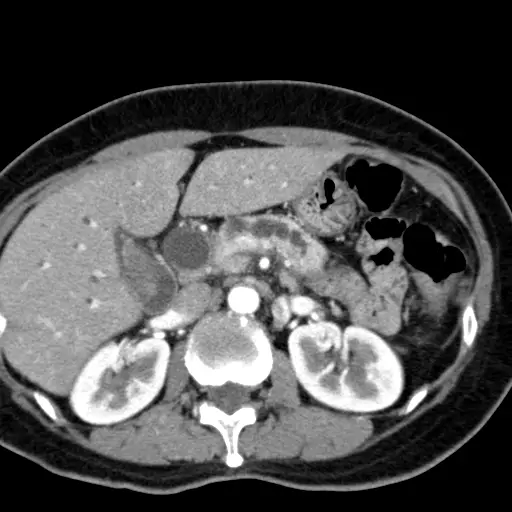
圖片

106年:醫學五(2)
65 歲林先生,近日來感覺疲倦、食慾減退、皮膚發黃。血液檢查肝功能異常、 CA-199 值升高。醫師為他做 CT檢查,影像如圖示。林先生最可能患了什麼病?

A肝內膽管癌( intrahepatic cholangiocarcinoma )
B肝細胞癌( hepatocellular carcinoma )
C胃癌(gastric cancer )
D胰臟頭癌( pancreatic head cancer )
詳細解析
本題觀念:
本題考核胰臟頭癌(pancreatic head cancer)的典型臨床表現與影像診斷。老年男性出現疲倦、食慾減退、皮膚黃疸(obstructive jaundice),合併 CA 19-9 升高,搭配 CT 及膽道攝影影像,是胰臟頭癌的典型呈現。
影像分析:
本題共提供三張影像:
影像一(膽道攝影 / ERCP cholangiogram): 可見肝內膽管明顯擴張,樹枝狀膽道系統顯影清晰,下方膽管出現截斷(abrupt cutoff),符合膽管遠端受壓阻塞的表現。同時可見胰管與總膽管同時擴張的「雙管徵(double duct sign)」,此為胰臟頭部或壺腹周圍腫瘤的高度特徵性影像表現。
影像二(腹部 CT 橫切面,胰臟層面): 在胰臟頭部區域可見一低密度(hypodense)腫塊,腫塊邊界不清,周圍正常胰臟實質受壓。總膽管(common bile duct, CBD)可見擴張。此種「乏血管性(hypovascular)」低密度腫塊在動脈期 CT 上相對於周圍正常胰臟實質呈低密度,是胰臟腺癌(pancreatic adenocarcinoma)的典型影像特徵。
影像三(腹部 CT 橫切面,肝臟層面): 肝臟內可見多發性圓形或管狀低密度結構,代表肝內膽管(intrahepatic bile ducts)瀰漫性擴張(int
...(解析預覽)...
![醫師[2] - 膽胰外科 - AI 圖文解析預覽](/_next/image?url=https%3A%2F%2Fbgvxfcrmbdvefjhuvrmt.supabase.co%2Fstorage%2Fv1%2Fobject%2Fpublic%2Fvisual-explanations%2F919%2F60965_t4i49674w.webp&w=3840&q=75)
升級 VIP 解鎖圖文解析